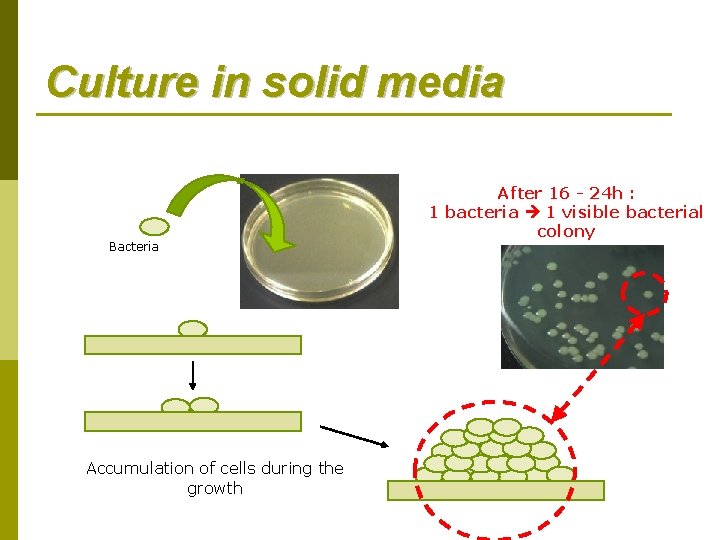
Culture in solid media Bacteria Accumulation of cells during the growth After 16 -

Bacterial culture in laboratory Bacterial culture in laboratory

Bacterial culture in laboratory

Bacterial culture in laboratory Introduction : bacterial growth

Bacterial growth p Multiplication by binary fission: bacteria grows and divides into identical daughter cells. the two p Characterized by a generation time (G) variable depending on the species 20 minutes for Escherichia coli, Lactobacillus acidophilus for 100 minutes, 1000 minutes to Mycobacterium tuberculosis

Bacterial growth

Bacterial growth After n cycles : 2 n bactéria

Bacterial growth For example, Escherichia coli G= 20 minutes p p p p After After … After 1 2 3 4 5 hour: 3 cycles : n = 23 = 8 bacteria hours: 6 cycles : n = 26 = 64 bacteria hours : 9 cycles : n = 29 = 512 bacteria hours : 12 cycles: n = 212 = 4096 bacteria hours : 15 cycles: n = 215 = 32768 bacteria 10 hours : 30 cycles : n = 230 = 1073741824 bacteria More than a billion bacteria after 10 hours of culture!

Bacterial culture in laboratory Culture media and inoculation technique

Culture media p Solid by adding a gelling agent (agar) to a liquid media p Liquid

Culture in liquid media Bacteria Increasing the cell density during the growth Clear media After 16 h of culture = turbid media
Culture in solid media Bacteria Accumulation of cells during the growth After 16 - 24 h : 1 bacteria 1 visible bacterial colony

Inoculation technique In liquid media : Inoculation with pipette Inoculation with loop In solid media (usually with Agar Petri dish) : Spreading with a rake Ridges with a loop Ridges with a swab

Bacterial culture in laboratory Aseptic conditions in lab

Aseptic conditions in lab Problem 1 : Bacteria from environment can contaminate the preparation Problem 2 : Bacteria can contaminate the technician Bacteria to study… Need a sterile zone around the preparation !! Problem 3 : Technician contaminate the preparation

Aseptic conditions in lab Equipment to create a sterile area to work… Microbiological Safety Cabinet : System which uses an HEPA filter (High Efficiency Particulate Air) to generate a flow of sterile air Protection for the preparation and the technician

Aseptic conditions in lab Equipment to create a sterile area to work… Bunsen Burner : Gas burner which delivers a flame at 1300°C provides a sterile air zone near

Aseptic conditions in lab Working with a Bunsen Burner : Sterile air area : Approximately 40 cm diameter around the burner Convection air movement This area is use to open tube or agar Petri dish with bacteria

Aseptic conditions in lab Organization of the workspace Bunsen Burner is place in the center of the workspace and all instruments are distributed around (aerial view) : Rack tubes Agar Petri dish Bunsen Burner Box with instruments (pipettes, inoculation loops…) Trash for contaminated instruments

Aseptic conditions in lab Organization of the workspace

Aseptic conditions in lab Consumables materials Most microbiology labs use sterile disposable equipment : Inoculation needles and loops Volumetric pipettes Spreading rake Pipettes
- Slides: 19